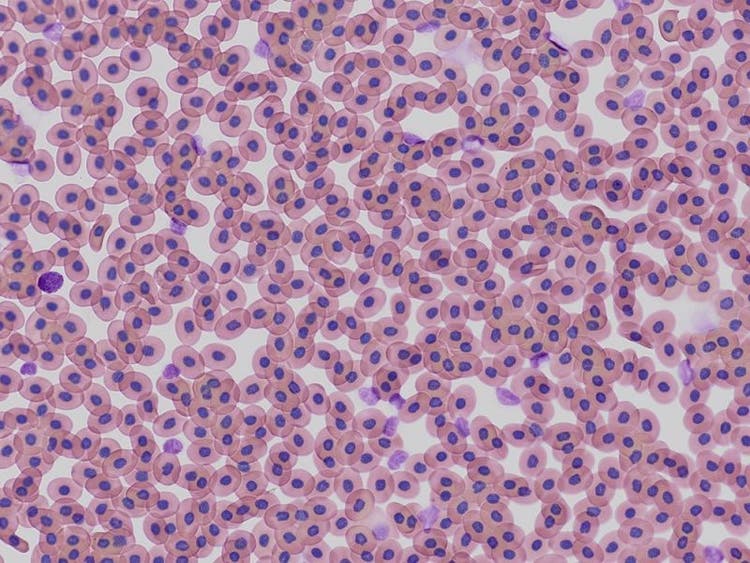
제노푸스 혈구의 적용 이미지

이미지 갤러리 APX100 디지털 이미징 시스템으로 캡처

APEXVIEW APX100 디지털 이미징 시스템은 다양한 관찰 방법을 지원합니다. 사용하기 쉽고 편리한 기능과 직관적인 소프트웨어를 통해 화질 저하 없이 다양한 연구를 보다 효율적으로 수행할 수 있습니다.
이 갤러리는 APX100 디지털 이미징 시스템을 사용하여 캡처한 적용 예시를 보여줍니다. 귀하의 분야에서 사용하는 방법에 대한 문의 사항이 있으시면 연락해 주십시오!

다채널 형광
- 다중 염색법을 사용한 샘플과 위상차나 구배 대비 같은 다른 이미징 모드와 조합하여 관찰합니다.
- 최대 8개의 미러 큐브 용량으로 다양한 실험 조건을 수용합니다.
- 각 채널의 자동 노출 시간과 Z 오프셋 보정으로 최적의 조건에서 신속하게 이미지를 캡처합니다.
- 병합된 이미지를 깔끔하게 표시하여 인식된 각 이미지가 사용자의 표준과 일치하도록 합니다.
BPAE 세포. 염색: 마우스 항-α-튜불린, BODIPY FL 염소 항-마우스 IgG, 텍사스 레드-X 팔로이딘, DAPI.
5가지 형광 염료를 사용하여 표지한 쥐의 소뇌
UV부터 NIR까지의 파장으로 다채널 형광 이미지를 손쉽게 획득하세요.
사용된 염료: 회흐스트(파란색), GFAP(녹색), MAP2(주황색), Calbindin(빨간색), MBP(자홍색).
대물렌즈: UPLXAPO4X


스티칭
- 전체 조직 샘플을 캡처하거나 넓은 영역에 걸쳐 고해상도로 세포 배양 플라스크의 상태를 빠르게 평가할 수 있습니다.
- 고정밀 스티칭은 명시야와 형광 획득 모드에서 이미지 사이의 이음매를 거의 보이지 않게 해줍니다.
- 고르지 않거나 기울어진 샘플도 깔끔하게 스티칭할 수 있습니다.
UPLXAPO4X 대물렌즈로 캡처한 마우스의 폐. 염색: HE.
Z 스택
- 두꺼운 샘플을 지원하기 위해 Z 방향으로 여러 이미지를 획득합니다.
- 단 몇 번의 클릭으로 올인포커스(all-in-focus) 이미지를 만듭니다.
- TruSight™ 3D 디콘볼루션을 사용하여 블러 없는 선명한 이미지를 얻습니다.
켄드린/페리센트린, 중심체 단백질의 세포하 국소화. 이미지 데이터 제공: Kazuhiko Matsuo, Ph.D., 교토부립 의과대학 발달생물학 및 해부학부 해부학과

타임랩스 이미징
- 시간이 지남에 따라 생세포 또는 전체 배양 세포가 어떻게 변하는지 지속적으로 기록합니다.
- 내장된 진동 방지 메커니즘과 선택 사항인 배양기 덕분에 안정적으로 이미지를 획득할 수 있습니다.
- 선택 사항인 투약 유닛과 결합하면 투약 직후의 세포 반응을 실시간으로 관찰할 수 있습니다.
스크래치 어세이
인간 대동맥 내피세포(HAEC)의 스크래치 어세이 타임랩스 이미징(2일).
이미지 데이터 제공: Dr. Kazutaka Ueda, 도쿄대학병원 심혈관과
마우스 수정란
수정된 마우스 난자에 대한 4시간의 타임랩스 관찰.
미토콘드리아에 대한 항산화 효과
H2O2 첨가로 산화된 미토콘드리아(강도 증가)가 나중에 항산화 효과에 의해 감소되었습니다(강도 감소).

이동하는 RBL-2H3 세포에 대한 다색 이미징
3가지 유형의 처치된 RBL-2H3 세포를 혼합하여 다색 타임랩스 이미징을 통해 이동 상태를 관찰했습니다. 대안적인 처치를 한 세포는 추적 분석에서 유사한 이동 상태를 보였습니다.
형광 이미징



형광현장혼성화법(FISH) 샘플
UPLXAPO60XO X Line™ 대물렌즈로 캡처.
원숭이 뇌의 NeuN 및 γ-H2AX 공동국소화
염색: 면역세포화학.
이미지 데이터 제공: Rui Han, 지난대학교 광둥-홍콩-마카오 CNS 재생 연구소, Xiaojiang-Li 교수의 연구실.
개암나무 꽃가루
UPLXAPO60X 오일 대물렌즈로 캡처한 자가 형광. TruSight 디콘볼루션으로 처리됩니다.



성체 마우스의 유선(Krt14/Krt8)
염색: 면역세포화학.
이미지 데이터 제공: Chunye Liu, CAS 분자 세포 과학 전문가 조직 Yi Zeng 교수 연구실
BSC-1 세포의 핵과 튜불린
염색: 면역세포화학, 흰색: 세포핵, 청록색: 튜불린.
투명해진 HeLa 세포 스페로이드
염색: 면역세포화학, 파란색: DAPI 핵, 녹색: AF488 Ki67, 빨간색: AF555 액틴.



Ptk2 세포
염색: DAPI, 미토트래커 레드, 액티스테인 488.
래트의 뇌 횡단면
염색: 회흐스트, RPCA-NF-L-ct 및 MCA-7D5.
마우스 신장
Alexa Fluor 488 WGA, Alexa Fluor 568 팔로이딘, DAPI.
명시야 이미징

알시안 블루 및 뉴클리어 패스트 레드 염색된 E15.5 마우스 배아
이미지 데이터 제공1.2.Naoki Takeshita, MD, 1.Kenta Yashiro 교수, MD, Ph.D., 1.교토부립 의과대학 발달생물학 및 해부학부, 해부학과 및 2.의학 대학원 소아과.
선종 조직 샘플
LUCPLFLN40XPH 대물렌즈로 캡처한 스티칭된 명시야 이미지. 이미지 데이터 제공: 독일 암 연구 센터(Deutsches Krebsforschungszentrum, DKFZ).
제노푸스 혈구
염색: HE.



옥수수 줄기 세포
염색: 사프라닌 메틸 블루.
WMISH(홀마운트 제자리 부합법, whole-mount in situ hybridization)에 의한 E9.5 마우스 배아의 Cyp26b1 발현 패턴
이미지 데이터 제공1.2.Naoki Takeshita, MD, 1.Kenta Yashiro 교수, MD, Ph.D., 1.교토부립 의과대학 발달생물학 및 해부학부, 해부학과 및 2.의학 대학원 소아과.
냉이 성숙 배아
염색: 삼색염색법.

구배 대비: 새로운 관점으로 샘플 보기
- 어떤 Olympus 대물렌즈과도 호환됩니다.
- 메니스커스, 용기 뚜껑, 물방울의 영향을 덜 받습니다.
- 유리 바닥 및 플라스틱 바닥 접시 그리고 멀티웰 플레이트와 함께 사용할 수 있습니다.
- 페트리 접시와 멀티웰 플레이트의 플라스틱 뚜껑을 통한 이미지 인식으로 오염 위험이 줄어듭니다.
HEK293T 세포에서 막(membrane) 전위된 mCherry의 발현. 이미지 데이터 제공: Rie Saba, Ph.D., 교토부립 의과대학 발달생물학 및 해부학부 해부학과
구배 대비로 캡처한 이미지

래트의 뇌

HEK-293 세포

래트의 정소


